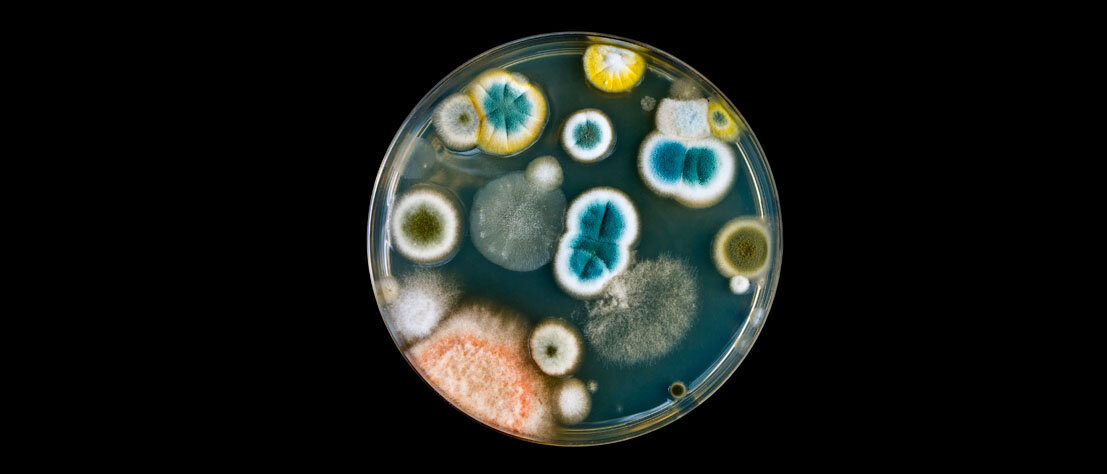

Studie
PILZINFEKTIONEN: DIE UNERKANNTE, TÖDLICHE GEFAHR
Seite 1/1 3 Minuten
Wir haben sie auf der Haut und im Darm, sie leben im Wasser und in der Luft: Schätzungsweise ein Viertel der gesamten Biomasse der Erde besteht aus Pilzen. Für gesunde Menschen sind sie kein Problem, denn unser Immunsystem erledigt sie mühelos. Wenn es allerdings angeschlagen ist, kann eine Infektion einen Menschen das Leben kosten. Dass diese Gefahr massiv unterschätzt wird, belegt eine neue Studie.
Die bislang unerkannte Gefahr ist schlecht dokumentiert. Selbst in wohlhabenden Ländern fehlen meist Testmöglichkeiten, werden nicht genutzt oder erkennen eine Infektion nicht zuverlässig. Der Infektionsmediziner und Mykologe David Denning nahm sich der Sache nun an und verglich die Zahlen offiziell diagnostizierter Pilzinfektionen aus den Jahren 2010 bis 2023 aus 120 Ländern und verglich diese mit Todeszahlen und Überlebensraten von behandelten und unbehandelten Infizierten.
Mehr Tote durch Pilze als durch Malaria und Tuberkulose
Das Ergebnis: Weltweit infizieren sich jährlich etwa 6,5 Millionen Menschen mit einem pathogenen Pilz. Rund 3,8 Millionen Menschen sterben infolge der Pilzerkrankung. Die Zahl dieser Art Infektionen hat sich innerhalb eines Jahrzehnts verdoppelt; jetzt „sind Pilze für 6,8 Prozent aller Todesfälle weltweit verantwortlich“, schreibt Denning. Damit töten sie sechsmal mehr Menschen als Malaria und dreimal mehr als Tuberkulose.
Dabei sind Pilze nicht unbedingt die Auslöser von Krankheiten. Doch sie tragen seinen Ergebnissen zufolge zum Tod der vorerkrankten Patienten bei, sagt Denning. Zum Beispiel Pilzinfektionen bei lungenkranken Menschen: Die seien kritisch. Zu den besonders tückischen Arten zählen die Schimmelpilze Aspergillus fumigatus und Aspergillus flavus.
Denning berechnete, dass etwa 30 Prozent der an Tuberkulose oder einer durchs Rauchen bedingten Lungenerkrankung Verstorbenen gleichzeitig mit einem Pilz infiziert waren – 1,8 Millionen Menschen sterben seiner Berechnung nach jedes Jahr an einer Aspergillus-Infektion.
Mehr zur Gefahr durch Mykosen:
Candida auris, der Überlebenskünstler
Gefährlich seien auch Candida, Hefepilze, daran stürben weltweit etwa eine Million Menschen. Die harmlosen Darmpilze werden dann gefährlich, wenn ihr Träger schwer krank ist – dann überwinden sie die Darmwand, dringen in den Blutkreislauf ein und können eine Blutvergiftung verursachen. Häufig betroffen sind Menschen mit Diabetes, mit Nierenversagen oder nach einer größeren Operation.
Vor allem Candida auris macht immer wieder von sich reden, denn er breitet sich seit einiger Zeit rasch aus. Bei immungeschwächten Patienten kann Candida auris eine invasive Candidose im Blut, im Herz, dem zentralen Nervensystem, Augen, Knochen und inneren Organen verursachen – das schrieb die Weltgesundheitsorganisation bereits vor einem Jahr. Die Mortalität bei dieser Pilzerkrankung liegt immerhin zwischen 29 und 53 Prozent.
Candida auris springt von Mensch zu Mensch, kann sich über Schmierinfektionen übertragen und wird immer resistenter gegen die gängigen Desinfektionsmittel.
Warnung vor präventivem Einsatz von Antimykotika
„Wir müssen Pilze sehr ernst nehmen“, mahnt Denning. „Es gibt keine Impfstoffe und teils auch keine wirksamen Medikamente.“ Dazu trage auch der Einsatz von Fungiziden in der Landwirtschaft bei.
„Pilzinfektionen wurden historisch vernachlässigt, verglichen mit dem Fokus auf bakterielle Infektionen und Antibiotika“, zeigt sich Tihana Bicanic, Professorin für Infektionskrankheiten und Mykologie in London wenig überrascht. Sie warnt vor dem übermäßigen Einsatz von Antimykotika, die von Krankenhäusern präventiv eingesetzt werden, beispielsweise bei Knochenmarkstransplantationen oder zur Behandlung von Hautinfektionen wie Fußpilz. Das trage nämlich zur Zunahme resistenter Pilze bei.
„Im Gegensatz zu Antibiotika haben wir etwa drei Klassen von Antimykotika, die wir häufig bei Patienten einsetzen“, sagt sie. „All diese Anwendungen üben Druck auf die Pilze aus, so dass sie sich anpassen und resistent werden können – und genau das passiert jetzt.“
Quellen:
https://www.n-tv.de/wissen/Wenn-Pilzinfektionen-toedlich-werden-article24685264.html
https://www.telegraph.co.uk/global-health/science-and-disease/fungal-disease-threat-on-the-rise-as-global-deaths-double/